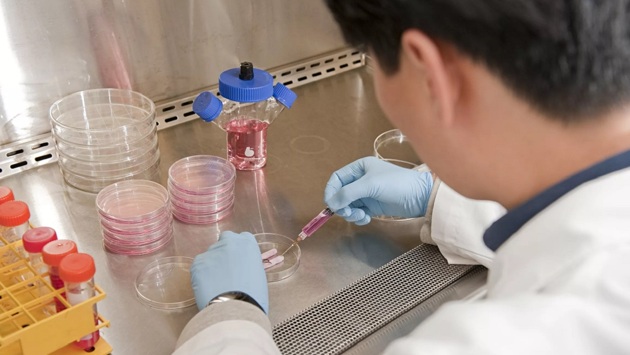

3D-визуализация позволит проектировать и выращивать искусственные биоткани на коллагеновых матрицах
Разработку провели ученые из Первого Московского государственного медицинского университета им. И.М. Сеченова. Теперь открыт способ выращивания биотканей на полимерных коллагеновых матрицах при помощи визуализации.
Исследователи обошли плохую контрастность коллагена и клеточных культур. Новый компонент позволяет «подсветить» коллаген в рентгеновских лучах, но при этом безопасен для живых клеток.
«Механизм действия химического соединения заключается в том, что оно прочно связывается с коллагеном и клеточными массами и обеспечивает их видимость при микро-КТ», — сообщил журналистам «Известий» младший научный сотрудник Института регенеративной медицины Сеченовского университета Сергей Ткачев.
Разработка поможет:
- в детальном моделировании биотканей;
- расчетах и прогнозировании изменений развития клеточных структур.
Впереди этап создания более сложных биоконструкций, например, гаджетов для биоэлектроники или «органов на чипе».
Ранее стало известно, что ученые нашли новый способ борьбы с глаукомой, секрет в генной терапии.